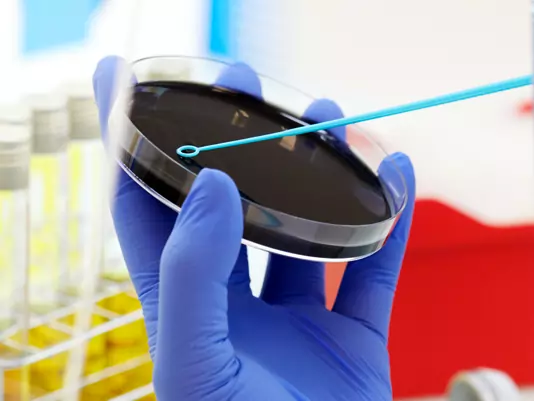

Verificación de métodos microbiológicos Norma ISO 16140-3:2021
100% bonificable por FUNDAE
Reglas de decisión (ILAC-G8:09/2019)
100% bonificable por FUNDAE
Consultoría de
calidad cercana
Gabinete de Servicios para la Calidad es tu solución. Una consultoría técnica y de calidad que ofrece un servicio integral y te ayuda en todo lo que necesites: desde implantar un sistema de gestión que garantice la eficacia y eficiencia de tu laboratorio, hasta ofrecerte asesoramiento en los aspectos más técnicos que requieras o formarte.
Somos expertos en facilitar la labor tanto de los laboratorios de ensayo como de las entidades de inspección. Nuestro objetivo es acompañarte en todo momento y conseguir mejorar tus resultados garantizando procesos técnicamente correctos, innovadores y eficientes.
Contamos con más de 25 años de experiencia colaborando con laboratorios nacionales de referencia, otros organismos oficiales y del sector privado, y estando a su lado gracias a nuestros consultores expertos y personal propio. Además, hace más de una década conseguimos ser el primer proveedor de Programas de Intercomparación Agroalimentarios acreditado por la ENAC (Acreditación nº 6/PPI011).
Tu consultoría cercana
Tu consultoría de calidad

¿Estás interesado en alguno de nuestros servicios?
Queremos ser tu partner en gestión técnica y de calidad
Tener un sistema de gestión de calidad bien implantado en tu organización es fundamental para:
- Poner en marcha una metodología de trabajo orientada a alcanzar los objetivos
- Identificar los procesos de trabajo en la empresa y orientarlos para satisfacer las necesidades de los clientes
- Definir cómo realizar las tareas del día a día de manera eficiente con los recursos que dispone la empresa
- Describir qué debe hacer cada persona en la organización para alcanzar los resultados esperados
- Saber cómo desarrollar una estrategia empresarial teniendo en cuenta los recursos humanos, económicos e infraestructurales
Te ayudamos en todas las funciones de tu empresa asumiendo actividades de soporte a través del servicio integral que ofrecemos y que abarca diferentes ámbitos relacionados con las principales normas en gestión de calidad.
Auditoría y Asesoría
Realizamos auditorías internas, también online, para verificar el cumplimiento de los requisitos normativos y técnicos del sistema y conseguir las acreditaciones que te propongas mediante un estudio de tu sistema de calidad gracias a la asesoría técnica que ofrecemos.
¿En qué quieres acreditarte o certificarte?
Intercomparativos
Verifica de forma externa tu laboratorio. ¡Te ayudamos!
¿Quieres ampliar el conocimiento de tu equipo?
Potenciamos tu formación profesional con nuestros cursos
La gestión de la calidad y la excelencia de tu organización se consigue con la especialización, que se adquiere con conocimiento y experiencia.
En GSC te ayudamos a especializarte. Impartimos una gran variedad de cursos en formato mixto, simultáneamente en streaming y presencial, con fecha programada que puedes consultar en nuestro calendario. Además, podemos diseñar formaciones personalizadas según tus necesidades.
¿Quieres un procedimiento u hoja de cálculo personalizado?
Ofrecemos soluciones que facilitan tus labores
¿Buscas productos que te permitan realizar calibraciones de manera interna o desarrollar cálculos para tus ensayos químicos o microbiológicos? En GSC tenemos hojas de cálculo y procedimientos y hojas de validación a tu alcance.
Nuestros clientes hablan por nosotros
En GSC nos apasiona hacer fácil lo difícil. Por eso, ofrecemos un amplio abanico de servicios de asesoría, auditoría y formación para conseguir implementar un sistema en gestión de calidad adecuado en tu organización.
Ponemos nuestra experiencia y conocimientos en tus manos para ayudarte a ahorrarte tiempo e impulsarte hacia el crecimiento y a la mejoría adaptándonos siempre a tus necesidades.
Las últimas noticias
¿Te gustaría informarte sobre el sector, conocer las tendencias del momento o las noticias más destacadas?
Descúbrelo todo en nuestro blog.
¿En qué podemos ayudarte?
Estamos aquí para lo que necesites. Obtén información más específica llamando al 91 551 92 52 o completa el formulario para que podamos contactar contigo y ayudarte. Nuestro equipo te asesorará lo antes posible.








